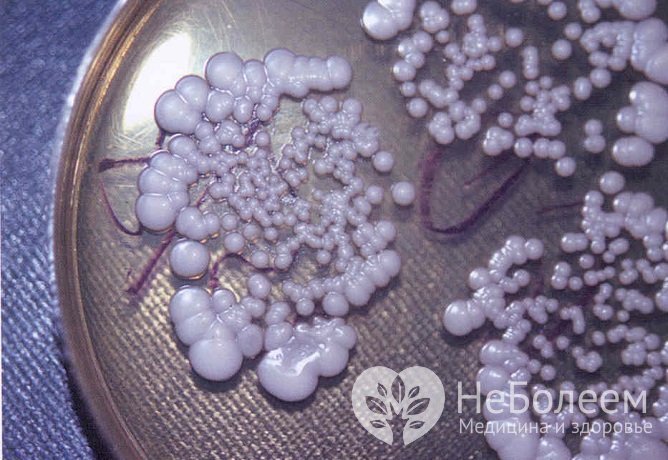
При микотическом поражении глотки возбудителем являются дрожжеподобные грибы рода Candida

Воспользуйтесь поиском по сайту:
Лечение фарингита антибиотиками у взрослых и детей
Содержание статьи:
Антибиотики при фарингите у взрослых и детей назначаются при лечении острого фарингита бактериальной этиологии или при затяжном, тяжелом течении заболевания. Проблема правильного подбора и рационального применения антибактериальных препаратов в настоящее время остается одной из наиболее актуальных тем в оториноларингологии.
 Назначать антибиотики для лечения фарингита должен врач
Назначать антибиотики для лечения фарингита должен врачПатогенные микроорганизмы из окружающей среды, попадая в организм человека на фоне сниженного общего и местного иммунитета, могут внедряться в слизистую оболочку глотки, вызывая ее воспаление – фарингит. Распространенность заболевания среди взрослого населения достигает 75%, а у детей – 30%.
По данным фармакологических и эпидемиологических исследований, в России антибиотики получают до 95% пациентов, у которых появились боли в горле. Подобная тактика не всегда обоснована. Нерациональный прием антибактериальных препаратов приводит к развитию резистентности большинства микроорганизмов.
Причины возникновения фарингита у взрослых и детей
Развитию острого воспаления слизистой оболочки глотки способствуют следующие факторы:
- переохлаждение организма;
- курение;
- прием алкоголя;
- горячая и холодная пища;
- пыль;
- загазованный воздух;
- длительное ротовое дыхание.
 Возбудителем фарингита может являться вирус гриппа
Возбудителем фарингита может являться вирус гриппаВ 40–70% случаев острый фарингит возникает в результате попадания в организм вирусов, поражающих слизистую оболочку верхних дыхательных путей:
- вирусы гриппа и парагриппа;
- риновирусы;
- аденовирусы;
- коронавирусы;
- энтеровирусы;
- вирус Эпштейна – Барр.
 Патогенами фарингита бактериальной этиологии могут быть стрептококки
Патогенами фарингита бактериальной этиологии могут быть стрептококкиФарингиты бактериальной этиологии составляют отдельную форму заболевания. При этом патогенами выступают стафилококки, стрептококки, внутриклеточные микроорганизмы (хламидии, микоплазмы).
При микотическом поражении глотки возбудителем являются дрожжеподобные грибы рода Candida
При микотическом поражении глотки возбудителем являются дрожжеподобные грибы рода CandidaПричиной микотического поражения глотки являются дрожжеподобные грибы рода Candida. Возможно сочетание бактериальной и грибковой флоры.
Кроме того, острый фарингит может возникнуть в результате механического, термического или химического поражения глотки, а также быть аллергической природы.
Симптомы фарингита
Основными жалобами пациентов с острым фарингитом являются:
- боль в горле при глотании, преимущественно при проглатывании слюны;
- чувство сухости, першения, жжения или дискомфорта в глотке;
- сухой кашель.
Ощущение стекания слизи по задней стенке глотки вынуждает пациента делать частые глотательные движения, что усугубляет боль в горле. Чаще всего фарингит протекает без температуры, но возможно повышение температуры тела до 37,1–37,9 °C, особенно у детей. При бактериальном поражении или тяжелом течении заболевания она может подниматься выше 38,0 °C.
В лечении воспалительного процесса слизистой оболочки глотки эффективны растительные антисептики и эфирные масла, но они противопоказаны пациентам, страдающим аллергией к пыльце растений.
При развитии острого фарингита возможно нисходящее воспаление с возникновением ларингита, трахеита, бронхита. У детей болезнь часто протекает с поражением слизистой оболочки полости носа (ринит) и миндалин (тонзиллит).
При хроническом фарингите пациент также может предъявлять жалобы на боль, дискомфорт и сухость в горле, но симптомы не так ярко выражены.
Читайте также:
Диагностика
Важную роль играет диагностика фарингита. При постановке диагноза врач опирается на данные анамнеза, клинические проявления и результаты исследований, таких как:
- фарингоскопия;
- экспресс-тест на стрептококк;
- бактериологический посев отделяемого и ПЦР-исследование (полимеразная цепная реакция);
- клинический анализ крови.
 При необходимости с диагностической целью проводится ПЦР-исследование
При необходимости с диагностической целью проводится ПЦР-исследованиеПроводится фарингоскопия, при которой определяется разлитая гиперемия задней стенки глотки, отек тканей и небных миндалин, возможен налет.
Бактериологическое исследование отделяемого из носа и зева направлено на выявление возбудителя и определение чувствительности бактерий к действию антибактериальных препаратов.
В диагностике стрептококкового фарингита большое значение играют экспресс-тесты, которые быстро определяют наличие возбудителя.
При обнаружении внутриклеточной инфекции (хламидии и микоплазмы) методом ПЦР принципы антибактериальной терапии могут меняться.
Клинический анализ крови может помочь в диагностике общего состояния организма и в дифференциальной диагностике вирусной или бактериальной инфекции.
Лечение фарингита
Лечение фарингита у взрослых и детей включает местную и системную терапию. Необходимо исключить из рациона раздражающую пищу: грубые, холодные, горячие, кислые продукты и блюда, газированные напитки. Следует максимально ограничить или исключить курение и прием алкоголя.
 При обострении болезни рекомендуются согревающие процедуры, в частности сухая повязка на шею и теплое обильное питье
При обострении болезни рекомендуются согревающие процедуры, в частности сухая повязка на шею и теплое обильное питьеПри первых признаках обострения или хроническом процессе рекомендуются согревающие процедуры:
- теплое обильное питье;
- горячие ножные ванны;
- сухая повязка на шею.
Можно ли вылечить без антибиотиков фарингит? Системная антибиотикотерапия обоснована при остром фарингите, вызванном пиогенным стрептококком или бета-гемолитическим стрептококком группы А. Также антибиотики назначаются при выявлении патогенной флоры по результатам посева и при затяжном, тяжелом течении заболевания.
Какие пить антибиотики, решает врач в зависимости от предполагаемого или установленного этиологического агента. Препаратом выбора для лечения острого бактериального или стрептококкового фарингита являются пенициллины: амоксициллин (Флемоксин Солютаб), амоксициллин + клавуланат (Амоксиклав), амоксициллин + сульбактам (Трифамокс).
Нужно помнить, что антибиотики не действуют на вирусы, не снижают температуру тела и не способствуют профилактике бактериальных осложнений.
Альтернативой могут быть цефалоспорины I поколения: цефазолин (Золин), цефалексин (Цефаклор), цефадроксил (Дурацеф). Названия препаратов, содержащих одно действующее вещество, могут различаться.
Перед назначением антибиотиков при фарингите у детей опираются также на результаты экспресс-теста на гемолитический стрептококк, оценивают тяжесть общего состояния. При выборе антибиотика необходимо учитывать возрастные ограничения и антибактериальную терапию, которую ребенок получал предшествующие 2–3 месяца.
Курс лечения фарингита антибиотиками у взрослых в среднем составляет 7–10 дней. Для эрадикации бета-гемолитического стрептококка группы А длительность терапии пенициллинами у детей и взрослых составляет 10 и 14 дней соответственно.
Перед назначением препаратов пенициллинового ряда проводят кожную пробу для оценки аллергической реакции. В случае аллергии на пенициллин в качестве препаратов выбора выступают цефалоспорины III поколения (Цефиксим), макролиды (Азитромицин) или линкозамиды (Линкомицин).
Местное лечение острого фарингита включает:
- топические лекарственные препараты (рассасывающие таблетки, спреи, растворы), оказывающие противовоспалительный, анальгезирующий, антибактериальный, противовирусный и иммунокоррегирующий эффект: Грамицидин, Гексорал, Октенисепт, Септолете, Стрепсилс, Тантум Верде;
- лизоцимсодержащие средства: Лизобакт, Ларипронт;
- топические иммуномодуляторы: Имудон, Имунорикс, ИРС-19, Рибомунил. Препараты представляют собой лизаты основных инфекционных возбудителей патологических процессов в верхних дыхательных путях и глотке. Они оказывают противовоспалительное, противоотечное, антибактериальное, противовирусное и противогрибковое действие;
- фитопрепараты с местным иммуностимулирующим действием: Тонзилгон Н, Тонзипрет, Элекасол, Ромазулан;
- топические нестероидные противовоспалительные средства: ОКИ (кетопрофен), Стрепфен (флурбипрофен);
- гомеопатические средства с антисептическим эффектом: Инфлюцид, Тонзилотрен, Фарингомед.
Показаны паровые ингаляции или полоскание глотки теплыми настоями ромашки, календулы, мяты или эвкалипта.
 Для паровых ингаляций могут применяться настои лекарственных трав
Для паровых ингаляций могут применяться настои лекарственных травВ лечении воспалительного процесса слизистой оболочки глотки эффективны растительные антисептики и эфирные масла, но они противопоказаны пациентам, страдающим аллергией к пыльце растений.
Для непосредственной доставки действующего вещества в верхние и нижние дыхательные пути рекомендуется применять небулайзер. Это устройство для ингаляций, которое превращает раствор в аэрозоль.
При развитии острого фарингита возможно нисходящее воспаление с возникновением ларингита, трахеита, бронхита. У детей болезнь часто протекает с поражением слизистой оболочки полости носа (ринит) и миндалин (тонзиллит).
Список необходимых для лечения препаратов, и как именно их принимать, определяет врач. Нужно помнить, что антибиотики не действуют на вирусы, не снижают температуру тела и не способствуют профилактике бактериальных осложнений. Назначение этих средств при вирусном фарингите ведет к развитию нежелательных лекарственных реакций и приводит к росту резистентности бактерий.
Необоснованное применение антибиотиков нарушает нормальную микрофлору организма. Важно соблюдать назначенную схему терапии, не следует преждевременно прекращать прием препарата или уменьшать суточную дозу, даже при улучшении состояния.
Видео
Предлагаем к просмотру видеоролик по теме статьи.
Об авторе

Опыт работы: 4 года работы в частной практике.
Нашли ошибку в тексте? Выделите ее и нажмите Ctrl + Enter.
Даже если сердце человека не бьется, то он все равно может жить в течение долгого промежутка времени, что и продемонстрировал нам норвежский рыбак Ян Ревсдал. Его "мотор" остановился на 4 часа после того как рыбак заблудился и заснул в снегу.
























